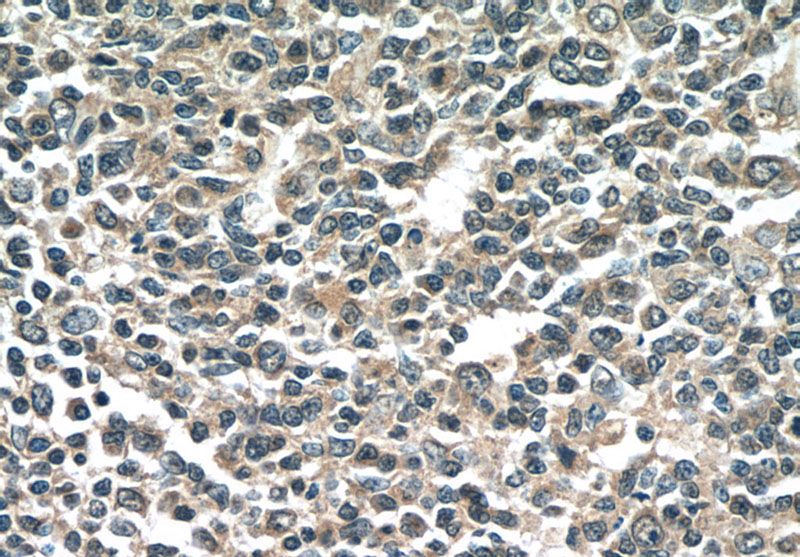
Immunohistochemistry of paraffin-embedded human tonsillitis tissue slide using Catalog No:107333(NINJ2 Antibody) at dilution of 1:50 (under 40x lens)

-
Product Name
NINJ2 antibody
- Documents
-
Description
NINJ2 Mouse Monoclonal antibody. Positive IHC detected in human tonsillitis tissue. Positive WB detected in Transfected HEK-293 cells.
-
Tested applications
ELISA, WB, IHC
-
Species reactivity
Human; other species not tested.
-
Alternative names
FLJ56349 antibody; Nerve injury induced protein 2 antibody; NINJ2 antibody; ninjurin 2 antibody
-
Isotype
Mouse IgG2b
-
Preparation
This antibody was obtained by immunization of NINJ2 recombinant protein (Accession Number: BC057766). Purification method: Protein A purified.
-
Clonality
Monoclonal
-
Formulation
PBS with 0.02% sodium azide and 50% glycerol pH 7.3.
-
Storage instructions
Store at -20℃. DO NOT ALIQUOT
-
Applications
Recommended Dilution:
WB: 1:500-1:5000
IHC: 1:20-1:200
-
Validations

Untransfected and NINJ2 transfected HEK-293 cells were subjected to SDS-PAGE followed by western blot with Catalog No:107333 (mouse anti-NINJ2 monoclonal antibody,1:1000) and mouse anti-6*His tag respectively.

Immunohistochemistry of paraffin-embedded human tonsillitis tissue slide using Catalog No:107333(NINJ2 Antibody) at dilution of 1:50 (under 10x lens)
Immunohistochemistry of paraffin-embedded human tonsillitis tissue slide using Catalog No:107333(NINJ2 Antibody) at dilution of 1:50 (under 40x lens)
-
Background
NINJ2 (Ninjurin2) is a member of the ninjurin family of adhesion molecules which mediate cell-to-cell and cell-to-extracellular matrix interactions during development, differentiation, and regeneration of the peripheral nervous system. The gene encodes NINJ2 is located on chromosome 12p13. NINJ2 mRNA is widely expressed in adult human tissues, with highest level in bone marrow, followed by peripheral leukocytes, lung, and lymph nodes. In the peripheral nervous system, NINJ2 is expressed constitutively in mature sensory and enteric neurons. The expression of NINJ2 is upregulated after nerve injury in Schwann cells, suggesting that it may promote nerve regeneration. It may also play an important role in the pathogenesis of inflammatory disorder. (PMID: 10627596)
Related Products / Services
Please note: All products are "FOR RESEARCH USE ONLY AND ARE NOT INTENDED FOR DIAGNOSTIC OR THERAPEUTIC USE"
